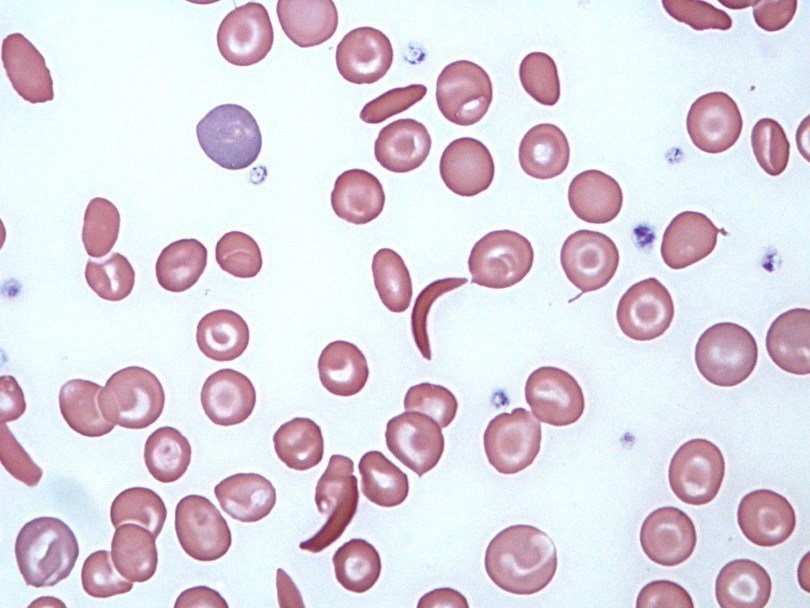

Максим Руссо: Новая победа генной терапии
Кровь с серповидными клетками scooterdmu/Flickr
Кровь с серповидными клетками scooterdmu/Flickr Французские ученые сообщили о первом в истории успешном применении генной терапии для излечения серповидноклеточной анемии.
В мире ежегодно рождается около 300 тысяч детей с серповидноклеточной анемией. Данная болезнь вызывается мутацией в гене, кодирующем одну из субчастиц молекулы гемоглобина. Она приводит к изменению формы белковой молекулы в красных клетках крови (вместо гемоглобина A появляется гемоглобин S). Эритроциты с дефектным гемоглобином имеют характерную серповидную форму, тогда как нормальные эритроциты имеют форму диска с вогнутой сердцевиной.
Серповидные эритроциты чаще обычных разрушаются, что влечет постоянную анемию, так как из-за гибели эритроцитов ткани недополучают кислород. К тому же такие эритроциты менее пластичны и хуже способны проходить через узкие капилляры. Частая закупорка капилляров у больных приводит к различным нарушениям, появлению тромбоза в печени и селезенке, артриту, язвам на ногах к тому же для них всегда характерна анемия и постоянная усталость. В некоторых случаях закупорка капилляров сетчатки глаза может привести к слепоте. Единственной формой непаллиативного лечения для таких больных до последнего времени была пересадка донорского костного мозга, но не для всех из них удается найти подходящего донора, к тому же трансплантация требует пожизненного применения препаратов, снижающих иммунитет.
Новый метод был сначала успешно испытан на животных, а в 2014 году в Детской больнице Неккер в Париже было начато первое клиническое испытание на человеке. Ученые работали с тринадцатилетним мальчиком с тяжелой формой серповидноклеточной анемии. Из-за последствий болезни у него развился двусторонний остеонекроз тазобедренного сустава, он также перенес удаление селезенки и желчного пузыря. Исследователи взяли у мальчика образец ткани его костного мозга. Из ткани были выделены мультипотентные гематопоэтические клетки. При помощи специально сконструированного вируса они внесли в его клетки гены другой формы гемоглобина. Причем они использовали не просто ген гемоглобина A, а добились замены в молекуле этого белка одной аминокислоты (глутамин на треонин). Этот вариант гена был обнаружен у некоторых детей, у которых ожидалось появление серповидноклеточной анемии, но ее симптомы не проявлялись.
После этого ученые использовали препарат бусульфан, чтобы уничтожить оставшиеся в организме мальчика кроветворные клетки. Такую процедуру обычно делают перед пересадкой костного мозга. Затем мальчику вернули взятые у него клетки с модифицированным теперь геном, ответственным за гемоглобин.
Примерно через полгода после процедуры уровень гемоглобина в крови мальчика достиг 106 – 120 граммов на литр (при норме для его возраста 110 – 160 граммов на литр). Частично это был гемоглобин S, частично – нормальный гемоглобин A. Через девять месяцев нормальный гемоглобин составлял 46 % от всего гемоглобина в организме, а спустя 15 месяцев после пересадки клеток нормального гемоглобина было уже 48 %. Такого количества гемоглобина А достаточно, чтобы симптомы серповидноклеточной анемии исчезли. На протяжении всех 15 месяцев у пациента не наблюдалось проявлений болезни. И врачи смогли отменить дополнительную терапию лекарствами и переливания крови. Исследователи будут в дальнейшем лишь наблюдать за состоянием крови мальчика, чтобы узнать, сохранится ли нормальный вариант гемоглобина в его организме и далее. Пока же можно сказать, что мальчик, в течение многих лет страдавший от тяжелой болезни, избавился от нее.
Сейчас клинические испытания аналогичного способа лечения проходят с участием еще ряда больных серповидноклеточной анемией и бета-талассемией (подробнее об этой болезни и применении генной терапии для ее лечения можно прочитать в специальном очерке). Сообщения об их результатах ожидаются.
Итоги исследования опубликовал New England Journal of Medicine.
Смотрите также: Скоро будет испытан генетический метод лечения серповидно-клеточной анемии Максим Руссо Вдова Линкольна и витамин B12 Александра Брутер Починка Т-лимфоцитов Александра Брутер Ученые выясняют, как наследуется бесплодие